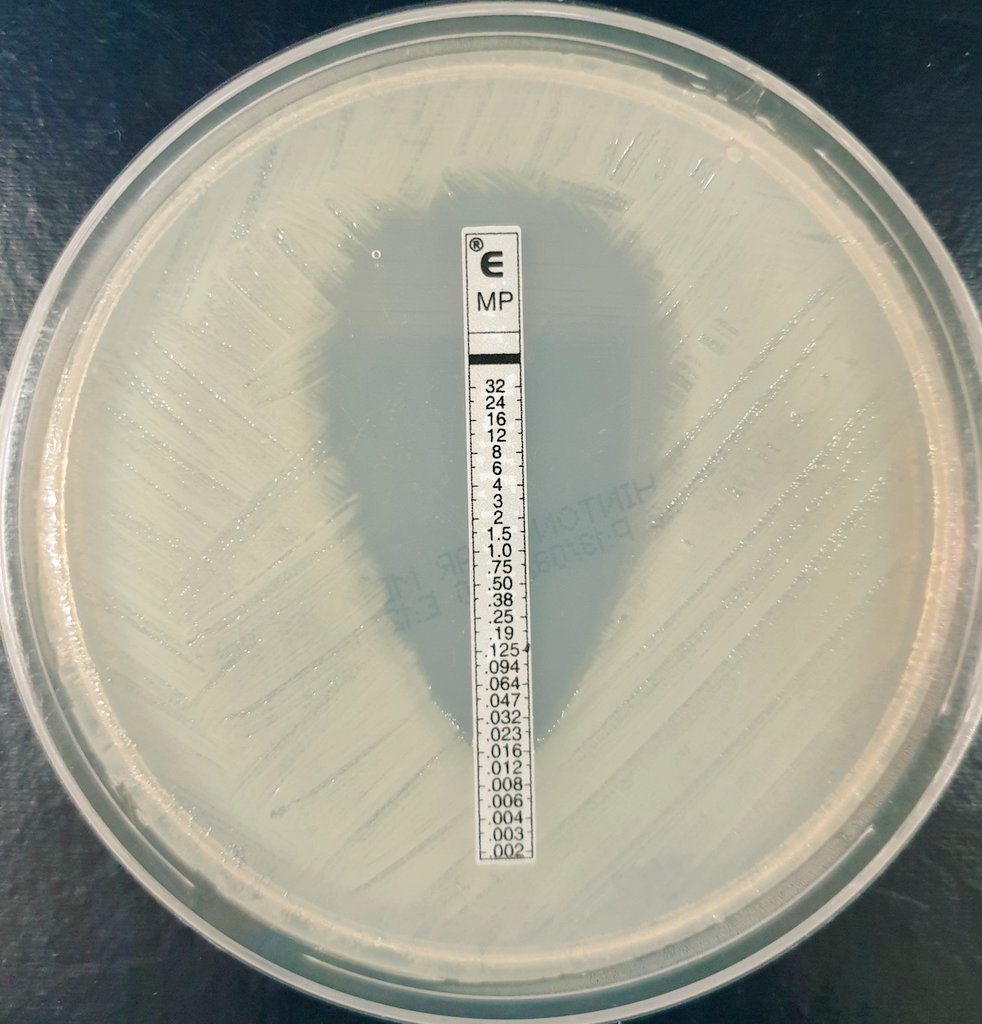

لا يمكن تقرر تجربة حساسية البكتريا لمضاد معين بدون ما تعرف اسم البكتريا تحديدا
قائمة المضادات اللي المفروض تجربها
=تعمل لها testing
تختلف اختلافا كليا بحسب الميكروب اللي طالع معك
وهنا سؤال؟
ألا يكفي إننا نحدد البكتريا دي
Gram positive or gram negative
وخلاص؟🤔
قائمة المضادات اللي المفروض تجربها
=تعمل لها testing
تختلف اختلافا كليا بحسب الميكروب اللي طالع معك
وهنا سؤال؟
ألا يكفي إننا نحدد البكتريا دي
Gram positive or gram negative
وخلاص؟🤔
أينعم البكتريا فيه بينها تشابه في موضوع الاستجابة للمضادات
وهتلاقي تشابه في المضادات اللي بتشتغل على ال
Gram positive bacteria
وتشابه أيضا بين المضادات اللي بتشتغل على ال
Gram negative bacteria
لكن رغم ذلك فيه اختلاف كبيييير
حتى بين أنواع البكتريا اللي كلنا نعرف انهم شبه بعض جدا
وهتلاقي تشابه في المضادات اللي بتشتغل على ال
Gram positive bacteria
وتشابه أيضا بين المضادات اللي بتشتغل على ال
Gram negative bacteria
لكن رغم ذلك فيه اختلاف كبيييير
حتى بين أنواع البكتريا اللي كلنا نعرف انهم شبه بعض جدا
فلك أن تتخيل مثلا إنه حتى
E. coli & Klebseilla
فيه بينهم اختلافات في ال
Antibiotics
المناسبة لكل واحدة فيهم
طيب مثال ثاني
أنواع ال pseudomonas المختلفة
E. coli & Klebseilla
فيه بينهم اختلافات في ال
Antibiotics
المناسبة لكل واحدة فيهم
طيب مثال ثاني
أنواع ال pseudomonas المختلفة
يعني لو البكتريا اللي معانا في الطبق
Pseudomembranous areoginosa
هتختلف عما لو كانتPseudomonas
من نوع ثاني مثل
Pseudomembranous fluorescence
هتخلف في المضادات وفي طريقة الشغل أيضا
الموضوع كبير 😁
خلاصة كلامنا اليوم إنه
1st step to do proper sensitivity is proper identification
Pseudomembranous areoginosa
هتختلف عما لو كانتPseudomonas
من نوع ثاني مثل
Pseudomembranous fluorescence
هتخلف في المضادات وفي طريقة الشغل أيضا
الموضوع كبير 😁
خلاصة كلامنا اليوم إنه
1st step to do proper sensitivity is proper identification
جاري تحميل الاقتراحات...